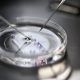

Lushi, a women-led start-up, has launched to offer treatments, clinics, and wellness platforms in order to help transform the IVF and egg freezing experience for women....
Researchers have identified Nr1h2, a critical transcription factor essential for early embryo development. The findings enhance our understanding of gene regulation during blastoid formation and hold...

Positive data has been reported from a pivotal trial of the infertility treatment FemaSeed intratubal insemination (ITI) – a type of artificial insemination designed to enhance...

A new AI system can accurately assess the chromosomal status of IVF embryos via time-lapse videos of the embryos and maternal age, data shows. The new...

In IVF treatment, embryos are traditionally transferred in the uterus three days after fertilisation. Due to improvements in laboratory techniques, this is now also possible after...

A groundbreaking study has demonstrated the potential of AI in optimising the ovarian stimulation process for IVF treatment. The study, led by Dr Chelsea Canon, a...

A new AI technology could assess the quality of live sperm in seconds, removing the need for invasive procedures that compromise sperm viability in IVF treatments....

The new content aims to support people experiencing fertility issues or undergoing treatment

In an era where inclusivity and employee wellbeing are paramount to corporate success, organisations are increasingly recognising the importance of comprehensive fertility benefits. This trend is...

By FinDBest IVF